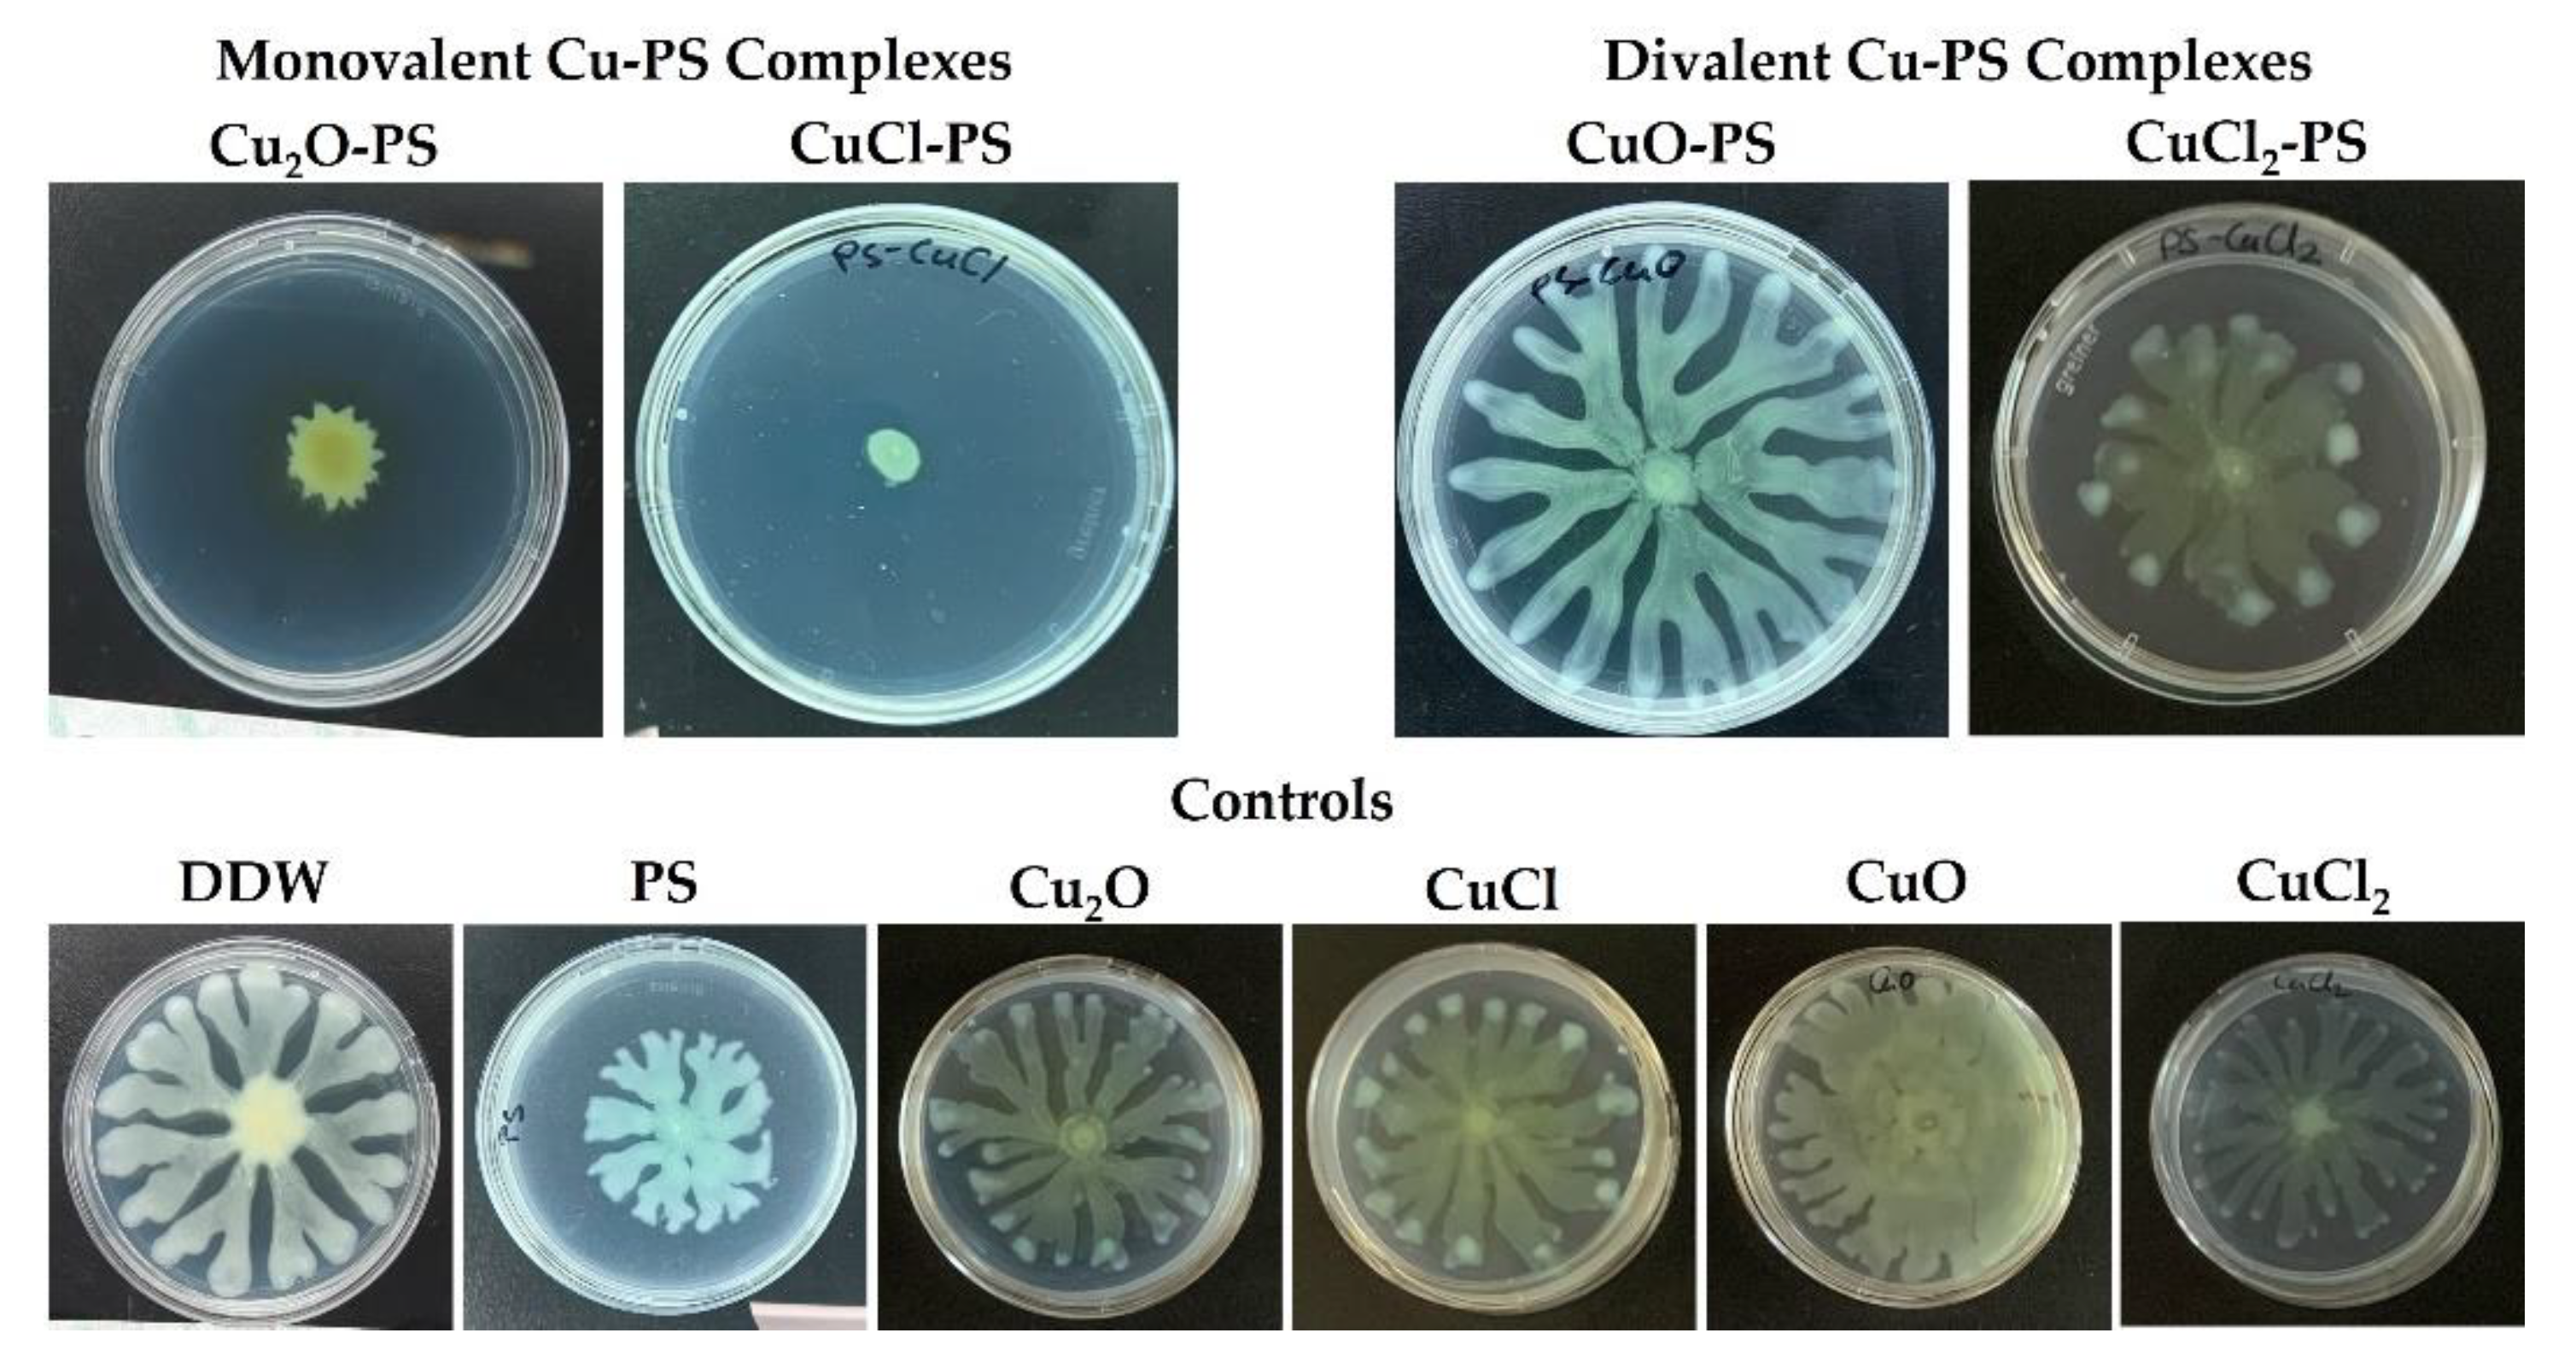
Marinedrugs 20 00787 g004

Complexes of Cu–Polysaccharide of a Marine Red Microalga Produce Spikes with Antimicrobial Activity
Abstract
1. Introduction
2. Results and Discussion
2.1. The Cu–PS Complexes: Physicochemical Characteristics
2.2. Antimicrobial and Antibiofilm Activities of Monovalent vs. Divalent Cu–PS Complexes
2.3. Surface Topography of the Cu-PS Complexes: Spike Nanotopography
2.4. Effect of Spikes on Perforation of Bacterial Membranes
3. Materials and Methods
3.1. Algal Growth and Polysaccharide Production
3.2. Preparation of Cu–PS Complexes
3.3. Physicochemical Characterization of Porphyridium sp. Polysaccharide Solutions
3.4. Fourier Transform Infrared (FTIR) Spectroscopy
3.5. Copper Release from the Cu–PS Complexes
3.6. Scanning Electron Microscopy/Energy Dispersive X-ray Spectroscopy (SEM-EDS) Analysis
3.7. Microbial Cultures and Growth Conditions
3.8. Microbial Growth Inhibition
3.9. Bacterial Surface Translocation
3.10. Confocal Laser Scanning Microscopy (CLSM)
3.11. Atomic Force Microscopy (AFM)
3.12. Antimicrobial and Antibiofilm Activities of Gold-Coated Cu–PS Complexes
3.13. Bioluminescence Accumulation Assay
4. Conclusions
Supplementary Materials
Author Contributions
Funding
Institutional Review Board Statement
Data Availability Statement
Acknowledgments
Conflicts of Interest
References
- Yu, Y.; Shen, M.; Song, Q.; Xie, J. Biological Activities and Pharmaceutical Applications of Polysaccharide from Natural Resources: A Review. Carbohydr. Polym. 2018, 183, 91–101. [Google Scholar] [CrossRef] [PubMed]
- Wang, X.Y.; Zhang, D.D.; Yin, J.Y.; Nie, S.P.; Xie, M.Y. Recent Developments in Hericium Erinaceus Polysaccharides: Extraction, Purification, Structural Characteristics and Biological Activities. Crit. Rev. Food Sci. Nutr. 2018, 59, S96–S115. [Google Scholar] [CrossRef] [PubMed]
- Li, X.; Jiang, F.; Liu, M.; Qu, Y.; Lan, Z.; Dai, X.; Huang, C.; Yue, X.; Zhao, S.; Pan, X.; et al. Synthesis, Characterization, and Bioactivities of Polysaccharide Metal Complexes: A Review. J. Agric. Food Chem. 2022, 70, 6922–6942. [Google Scholar] [CrossRef]
- Xu, Y.; Wu, Y.; Sun, P.; Zhang, F.; Linhardt, R.J.; Zhang, A. Chemically Modified Polysaccharides: Synthesis, Characterization, Structure Activity Relationships of Action. Int. J. Biol. Macromol. 2019, 132, 970–977. [Google Scholar] [CrossRef]
- Lapidot, M.; Shrestha, R.P.; Weinstein, Y.; Arad, S. Red Microalgae: From Basic Know-How to Biotechnology; Springer: Berlin/Heidelberg, Germany, 2010; pp. 205–225. [Google Scholar]
- Arad, S.; van Moppes, D. Novel Sulfated Polysaccharides of Red Microalgae: Basics and Applications. In Handbook of Microalgal Culture: Applied Phycology and Biotechnology; Wiley: Hoboken, NJ, USA, 2013; pp. 406–416. [Google Scholar]
- Arad, S.; Levy-Ontman, O. Red Microalgal Cell-Wall Polysaccharides: Biotechnological Aspects. Curr. Opin. Biotechnol. 2010, 21, 358–364. [Google Scholar] [CrossRef] [PubMed]
- Geresh, S.; Arad, S. The Extracellular Polysaccharides of the Red Microalgae: Chemistry and Rheology. Bioresour. Technol. 1991, 38, 195–201. [Google Scholar] [CrossRef]
- Lupescu, N.; Arad, S.; Geresh, S.; Bernstein, M.A.; Glaser, R. Structure of Some Sulfated Sugars Isolated after Acid Hydrolysis of the Extracellular Polysaccharide of Porphyridium sp., a Unicellular Red Alga. Carbohydr. Res. 1991, 210, 349–352. [Google Scholar] [CrossRef]
- Arad, S.; Levy-Ontman, O. Sulfated Polysaccharides in the Cell Wall of Red Microalgae. In Handbook of Biopolymer-Based Materials: From Blends and Composites to Gels and Complex Networks; Wiley: Hoboken, NJ, USA, 2013; pp. 351–370. [Google Scholar]
- Tannin-Spitz, T.; Bergman, M.; Van-Moppes, D.; Grossman, S.; Arad, S. Antioxidant Activity of the Polysaccharide of the Red Microalga Porphyridium sp. J. Appl. Phycol. 2005, 17, 215–222. [Google Scholar] [CrossRef]
- Matsui, M.S.; Muizzuddin, N.; Arad, S.; Marenus, K. Sulfated Polysaccharides from Red Microalgae Have Antiinflammatory Properties In Vitro and In Vivo. Appl. Biochem. Biotechnol.—Part A Enzym. Eng. Biotechnol. 2003, 104, 13–22. [Google Scholar] [CrossRef]
- Arad, S.; Rapoport, L.; Moshkovich, A.; Van Moppes, D.; Karpasas, M.; Golan, R.; Golan, Y. Superior Biolubricant from a Species of Red Microalga. Langmuir 2006, 22, 7313–7317. [Google Scholar] [CrossRef]
- Huleihel, M.; Ishanu, V.; Tal, J.; Arad, S. Antiviral Effect of Red Microalgal Polysaccharides on Herpes Simplex and Varicella Zoster Viruses. J. Appl. Phycol. 2001, 13, 127–134. [Google Scholar] [CrossRef]
- Talyshinsky, M.M.; Souprun, Y.Y.; Huleihel, M.M. Anti-Viral Activity of Red Microalgal Polysaccharides against Retroviruses. Cancer Cell Int. 2002, 2, 8. [Google Scholar] [CrossRef] [PubMed]
- Yehuda, N.; Turkulets, Y.; Shalish, I.; Kushmaro, A.; Arad, S. Red Microalgal Sulfated Polysaccharide-Cu2O Complexes: Characterization and Bioactivity. ACS Appl. Mater. Interfaces 2021, 13, 7070–7079. [Google Scholar] [CrossRef] [PubMed]
- Golberg, K.; Emuna, N.; Vinod, T.P.; Van Moppes, D.; Marks, R.S.; Arad, S.; Kushmaro, A. Novel Anti-Adhesive Biomaterial Patches: Preventing Biofilm with Metal Complex Films (MCF) Derived from a Microalgal Polysaccharide. Adv. Mater. Interfaces 2016, 3, 1500486. [Google Scholar] [CrossRef]
- Dvir, I.; Chayoth, R.; Sod-Moriah, U.; Shany, S.; Nyska, A.; Stark, A.H.; Madar, Z.; Arad, S. Soluble Polysaccharide and Biomass of Red Microalga Porphyridium sp. Alter Intestinal Morphology and Reduce Serum Cholesterol in Rats. Br. J. Nutr. 2000, 84, 469–476. [Google Scholar] [CrossRef] [PubMed]
- Dvir, I.; vam Moppes, D.; Arad, S.M. Foodomics: To Discover the Health Potential of Microalgae. In Comprehensive Foodomics; Elsevier: Amsterdam, The Netherlands, 2021; Volume 3, pp. 658–671. [Google Scholar]
- Hawi, S.; Goel, S.; Kumar, V.; Pearce, O.; Ayre, W.N.; Ivanova, E.P. Critical Review of Nanopillar-Based Mechanobactericidal Systems. ACS Appl. Nano Mater. 2021, 2022, 1–17. [Google Scholar] [CrossRef]
- Modaresifar, K.; Azizian, S.; Ganjian, M.; Fratila-Apachitei, L.E.; Zadpoor, A.A. Bactericidal Effects of Nanopatterns: A Systematic Review. Acta Biomater. 2019, 83, 29–36. [Google Scholar] [CrossRef]
- Linklater, D.P.; Baulin, V.A.; Juodkazis, S.; Crawford, R.J.; Stoodley, P.; Ivanova, E.P. Mechano-Bactericidal Actions of Nanostructured Surfaces. Nat. Rev. Microbiol. 2021, 19, 8–22. [Google Scholar] [CrossRef]
- Jenkins, J.; Mantell, J.; Neal, C.; Gholinia, A.; Verkade, P.; Nobbs, A.H.; Su, B. Antibacterial Effects of Nanopillar Surfaces Are Mediated by Cell Impedance, Penetration and Induction of Oxidative Stress. Nat. Commun. 2020, 11, 1–14. [Google Scholar]
- Nowlin, K.; Boseman, A.; Covell, A.; LaJeunesse, D. Adhesion-Dependent Rupturing of Saccharomyces Cerevisiae on Biological Antimicrobial Nanostructured Surfaces. J. R. Soc. Interface 2014, 12, 20140999. [Google Scholar] [CrossRef]
- Bandara, C.D.; Singh, S.; Afara, I.O.; Wolff, A.; Tesfamichael, T.; Ostrikov, K.; Oloyede, A. Bactericidal Effects of Natural Nanotopography of Dragonfly Wing on Escherichia Coli. ACS Appl. Mater. Interfaces 2017, 9, 6746–6760. [Google Scholar] [CrossRef] [PubMed]
- Pogodin, S.; Hasan, J.; Baulin, V.A.; Webb, H.K.; Truong, V.K.; Phong Nguyen, T.H.; Boshkovikj, V.; Fluke, C.J.; Watson, G.S.; Watson, J.A.; et al. Biophysical Model of Bacterial Cell Interactions with Nanopatterned Cicada Wing Surfaces. Biophys. J. 2013, 104, 835–840. [Google Scholar] [CrossRef] [PubMed]
- Hazell, G.; Fisher, L.E.; Murray, W.A.; Nobbs, A.H.; Su, B. Bioinspired Bactericidal Surfaces with Polymer Nanocone Arrays. J. Colloid Interface Sci. 2018, 528, 389–399. [Google Scholar] [CrossRef] [PubMed]
- Silhavy, T.J.; Kahne, D.; Walker, S. The Bacterial Cell Envelope. Cold Spring Harb. Perspect. Biol. 2010, 2, a000414. [Google Scholar] [CrossRef]
- Kelleher, S.M.; Habimana, O.; Lawler, J.; O’reilly, B.; Daniels, S.; Casey, E.; Cowley, A. Cicada Wing Surface Topography: An Investigation into the Bactericidal Properties of Nanostructural Features. ACS Appl. Mater. Interfaces 2016, 8, 14966–14974. [Google Scholar] [CrossRef]
- Elbourne, A.; Chapman, J.; Gelmi, A.; Cozzolino, D.; Crawford, R.J.; Truong, V.K. Bacterial-Nanostructure Interactions: The Role of Cell Elasticity and Adhesion Forces. J. Colloid Interface Sci. 2019, 546, 192–210. [Google Scholar] [CrossRef]
- Arias, S.L.; Devorkin, J.; Spear, J.C.; Civantos, A.; Paul Allain, J. Bacterial Envelope Damage Inflicted by Bioinspired Nanospikes Grown in a Hydrogel. ACS Appl. Bio Mater. 2020, 3, 7974–7988. [Google Scholar] [CrossRef]
- Luan, B.; He, J.; Hu, H.; Li, L.; Tian, F.; Chang, H.; Zhang, J.; Wang, C.; Rao, W. Interactions of Bacteria With Monolithic Lateral Silicon Nanospikes Inside a Microfluidic Channel. Front. Chem. 2019, 7, 483. [Google Scholar]
- Park, S.; Park, H.-H.; Sun, K.; Gwon, Y.; Seong, M.; Kim, S.; Park, T.-E.; Hyun, H.; Choung, Y.-H.; Kim, J.; et al. Hydrogel Nanospike Patch as a Flexible Anti-Pathogenic Scaffold for Regulating Stem Cell Behavior Many Types of Artificial Biomaterials with Nanotopographic Article. ACS Nano 2021, 12, 48. [Google Scholar]
- Tripathy, A.; Sen, P.; Su, B.; Briscoe, W.H. Natural and Bioinspired Nanostructured Bactericidal Surfaces. Adv. Colloid Interface Sci. 2017, 248, 85–104. [Google Scholar] [CrossRef]
- Linklater, D.P.; Juodkazis, S.; Rubanov, S.; Ivanova, E.P. Comment on “Bactericidal Effects of Natural Nanotopography of Dragonfly Wing on Escherichia Coli”. ACS Appl. Mater. Interfaces 2017, 9, 54. [Google Scholar] [CrossRef] [PubMed]
- Crawford, R.J.; Webb, H.K.; Truong, V.K.; Hasan, J.; Ivanova, E.P. Surface Topographical Factors Influencing Bacterial Attachment. Adv. Colloid Interface Sci. 2012, 179–182, 142–149. [Google Scholar] [CrossRef] [PubMed]
- Elbourne, A.; Coyle, V.E.; Truong, V.K.; Sabri, Y.M.; Kandjani, A.E.; Bhargava, S.K.; Ivanova, E.P.; Crawford, R.J. Multi-Directional Electrodeposited Gold Nanospikes for Antibacterial Surface Applications. Nanoscale Adv. 2019, 1, 203–212. [Google Scholar] [CrossRef] [PubMed]
- Rani, H.; Singh, S.P.; Yadav, T.P.; Khan, M.S.; Ansari, M.I.; Singh, A.K. In-Vitro Catalytic, Antimicrobial and Antioxidant Activities of Bioengineered Copper Quantum Dots Using Mangifera Indica (L.). Leaf Extract. Mater. Chem. Phys. 2020, 239, 122052. [Google Scholar] [CrossRef]
- Jiao, J.; Zhang, S.; Qu, X.; Yue, B. Recent Advances in Research on Antibacterial Metals and Alloys as Implant Materials. Front. Cell. Infect. Microbiol. 2021, 11, 611. [Google Scholar] [CrossRef] [PubMed]
- Ingle, A.P.; Duran, N.; Rai, M. Bioactivity, Mechanism of Action, and Cytotoxicity of Copper-Based Nanoparticles: A Review. Appl. Microbiol. Biotechnol. 2014, 98, 1001–1009. [Google Scholar] [CrossRef] [PubMed]
- Lin, Y.S.E.; Vidic, R.D.; Stout, J.E.; McCartney, C.A.; Yu, V.L. Inactivation of Mycobacterium Avium by Copper and Silver Ions. Water Res. 1998, 32, 1997–2000. [Google Scholar] [CrossRef]
- Ingle, A.; Gade, A.; Pierrat, S.; Sonnichsen, C.; Rai, M. Mycosynthesis of Silver Nanoparticles Using the Fungus Fusarium Acuminatum and Its Activity against Some Human Pathogenic Bacteria. Curr. Nanosci. 2008, 4, 141–144. [Google Scholar] [CrossRef]
- Weir, E.; Lawlor, A.; Whelan, A.; Regan, F. The Use of Nanoparticles in Anti-Microbial Materials and Their Characterization. Analyst 2008, 133, 835–845. [Google Scholar] [CrossRef]
- Kroll, S.; Brandes, C.; Wehling, J.; Treccani, L.; Grathwohl, G.; Rezwan, K. Highly Efficient Enzyme-Functionalized Porous Zirconia Microtubes for Bacteria Filtration. Environ. Sci. Technol. 2012, 46, 8739–8747. [Google Scholar] [CrossRef]
- Wehling, J.; Köser, J.; Lindner, P.; Lüder, C.; Beutel, S.; Kroll, S.; Rezwan, K. Silver Nanoparticle-Doped Zirconia Capillaries for Enhanced Bacterial Filtration. Mater. Sci. Eng. C 2015, 48, 179–187. [Google Scholar] [CrossRef] [PubMed]
- Li, Q.; Mahendra, S.; Lyon, D.Y.; Brunet, L.; Liga, M.V.; Li, D.; Alvarez, P.J.J. Antimicrobial Nanomaterials for Water Disinfection and Microbial Control: Potential Applications and Implications. Water Res. 2008, 42, 4591–4602. [Google Scholar] [CrossRef] [PubMed]
- Fahmy, B.; Cormier, S.A. Copper Oxide Nanoparticles Induce Oxidative Stress and Cytotoxicity in Airway Epithelial Cells. Toxicol. Vitr. 2009, 23, 1365–1371. [Google Scholar] [CrossRef] [PubMed]
- Flemming, C.A.; Trevors, J.T. Copper Toxicity and Chemistry in the Environment: A Review. Water. Air. Soil Pollut. 1989, 44, 143–158. [Google Scholar] [CrossRef]
- Hsiao, M.T.; Chen, S.F.; Shieh, D.B.; Yeh, C.S. One-Pot Synthesis of Hollow Au3Cu1 Spherical-like and Biomineral Botallackite Cu2(OH)3Cl Flowerlike Architectures Exhibiting Antimicrobial Activity. J. Phys. Chem. B 2006, 110, 205–210. [Google Scholar] [CrossRef]
- Harrison, J.J.; Ceri, H.; Stremick, C.A.; Turner, R.J. Biofilm Susceptibility to Metal Toxicity. Environ. Microbiol. 2004, 6, 1220–1227. [Google Scholar] [CrossRef]
- Klein, T.Y.; Wehling, J.; Treccani, L.; Rezwan, K. Effective Bacterial Inactivation and Removal of Copper by Porous Ceramics with High Surface Area. Environ. Sci. Technol. 2013, 47, 1065–1072. [Google Scholar] [CrossRef] [PubMed]
- Ruparelia, J.P.; Chatterjee, A.K.; Duttagupta, S.P.; Mukherji, S. Strain Specificity in Antimicrobial Activity of Silver and Copper Nanoparticles. Acta Biomater. 2008, 4, 707–716. [Google Scholar] [CrossRef]
- Hassan, I.A.; Parkin, I.P.; Nair, S.P.; Carmalt, C.J. Antimicrobial Activity of Copper and Copper(i) Oxide Thin Films Deposited via Aerosol-Assisted CVD. J. Mater. Chem. B 2014, 2, 2855–2860. [Google Scholar] [CrossRef]
- Zhang, E.; Zhao, X.; Hu, J.; Wang, R.; Fu, S.; Qin, G. Antibacterial Metals and Alloys for Potential Biomedical Implants. Bioact. Mater. 2021, 6, 2569–2612. [Google Scholar] [CrossRef]
- Aderolu, H.A.; Aboaba, O.O.; Aderolu, A.Z.; Abdulwahab, K.O.; Suliman, A.A.; Emmanuel, U.C. Biological Synthesis of Copper Nanoparticles and Its Antimicrobial Potential on Selected Bacteria Food-Borne Pathogens. Ife J. Sci. 2021, 23, 11–21. [Google Scholar] [CrossRef]
- Pontin, K.P.; Borges, K.A.; Furian, T.Q.; Carvalho, D.; Wilsmann, D.E.; Cardoso, H.R.P.; Alves, A.K.; Chitolina, G.Z.; Salle, C.T.P.; de Souza Moraes, H.L.; et al. Antimicrobial Activity of Copper Surfaces against Biofilm Formation by Salmonella Enteritidis and Its Potential Application in the Poultry Industry. Food Microbiol. 2021, 94, 103645. [Google Scholar] [CrossRef] [PubMed]
- Mohamed, A. Bionanoparticles from Moringa as Antimicrobial Activity and It’s Application in Water Purification: Thesis Abstract. Int. J. Cancer Biomed. Res. 2021, 5, 5. [Google Scholar] [CrossRef]
- Geresh, S.; Arad, S.; Shefer, A. Chemically Crosslinked Polysaccharide of the Red Microalga Rhodella Reticulata—An Ion Exchanger for Toxic Metal Ions. J. Carbohydr. Chem. 1997, 16, 703–708. [Google Scholar] [CrossRef]
- Netanel Liberman, G.; Ochbaum, G.; Arad, S.; Bitton, R. The Sulfated Polysaccharide from a Marine Red Microalga as a Platform for the Incorporation of Zinc Ions. Carbohydr. Polym. 2016, 152, 658–664. [Google Scholar] [CrossRef]
- Netanel Liberman, G.; Ochbaum, G.; Bitton, R.; Arad, S. Antimicrobial Hydrogels Composed of Chitosan and Sulfated Polysaccharides of Red Microalgae. Polymer 2021, 215, 123353. [Google Scholar] [CrossRef]
- Gómez-Ordóñez, E.; Rupérez, P. FTIR-ATR Spectroscopy as a Tool for Polysaccharide Identification in Edible Brown and Red Seaweeds. Food Hydrocoll. 2011, 25, 1514–1520. [Google Scholar] [CrossRef]
- Synytsya, A.; Kim, W.J.; Kim, S.M.; Pohl, R.; Synytsya, A.; Kvasnička, F.; Čopíková, J.; IL Park, Y. Structure and Antitumour Activity of Fucoidan Isolated from Sporophyll of Korean Brown Seaweed Undaria Pinnatifida. Carbohydr. Polym. 2010, 81, 41–48. [Google Scholar] [CrossRef]
- Rupérez, P. Mineral Content of Edible Marine Seaweeds. Food Chem. 2002, 79, 23–26. [Google Scholar] [CrossRef]
- Leal, D.; Matsuhiro, B.; Rossi, M.; Caruso, F. FT-IR Spectra of Alginic Acid Block Fractions in Three Species of Brown Seaweeds. Carbohydr. Res. 2008, 343, 308–316. [Google Scholar] [CrossRef]
- Christensen, B.B.; Sternberg, C.; Andersen, J.B.; Palmer, R.J.; Nielsen, A.T.; Givskov, M.; Molin, S. [2] Molecular Tools for Study of Biofilm Physiology. Methods Enzymol. 1999, 310, 20–42. [Google Scholar] [PubMed]
- Falagas, M.E.; Bliziotis, I.A. Pandrug-Resistant Gram-Negative Bacteria: The Dawn of the Post-Antibiotic Era? Int. J. Antimicrob. Agents 2007, 29, 630–636. [Google Scholar] [CrossRef] [PubMed]
- O’Loughlin, C.T.; Miller, L.C.; Siryaporn, A.; Drescher, K.; Semmelhack, M.F.; Bassler, B.L. A Quorum-Sensing Inhibitor Blocks Pseudomonas Aeruginosa Virulence and Biofilm Formation. Proc. Natl. Acad. Sci. USA 2013, 110, 17981–17986. [Google Scholar] [CrossRef] [PubMed]
- Jia, K.; Marks, R.S.; Ionescu, R.E. Influence of Carbon-Based Nanomaterials on Lux-Bioreporter Escherichia Coli. Talanta 2014, 126, 208–213. [Google Scholar] [CrossRef]
- Jones, R.F.; Speer, H.L.; Kury, W. Studies on the Growth of the Red Alga Porphyridium Cruentum. Physiol. Plant. 1963, 16, 636–643. [Google Scholar] [CrossRef]
- Arad, S.; Adda, M.; Cohen, E. The Potential of Production of Sulfated Polysaccharides from Porphyridium. Plant Soil 1985, 89, 117–127. [Google Scholar] [CrossRef]
- Dubois, M.; Gilles, K.A.; Hamilton, J.K.; Rebers, P.A.; Smith, F. Colorimetric Method for Determination of Sugars and Related Substances. Anal. Chem. 1956, 28, 350–356. [Google Scholar] [CrossRef]
- Harpaz, D.; Yeo, L.P.; Cecchini, F.; Koon, T.H.P.; Kushmaro, A.; Tok, A.I.Y.; Marks, R.S.; Eltzov, E. Measuring Artificial Sweeteners Toxicity Using a Bioluminescent Bacterial Panel. Molecules 2018, 23, 2454. [Google Scholar] [CrossRef]

| Monovalent Cu–PS Complexes | Divalent Cu–PS Complexes | Control | |||
|---|---|---|---|---|---|
| Cu2O–PS | CuCl–PS | CuO–PS | CuCl2–PS | Polysaccharide | |
| Viscosity [cP] | 2415.3 ± 60.5 | 2230.0 ± 72.1 | 1978.3 ± 24.8 | 1979.0 ± 18.3 | 1733.7 ± 129.8 |
| Conductivity [µS] | 3303.0 ± 265.6 | 2930.7 ± 122.2 | 1943.3 ± 50.3 | 1230.0 ± 81.9 | 1043.3 ± 92.9 |
| ζ-potential [mV] | −72.5 ± 1.3 | −65.7 ± 4.1 | −43.6 ± 0.5 | −33.9 ± 0.3 | −67.5 ± 2.3 |
| pH | 6.3 ± 0.7 | 6.4 ± 0.9 | 6.1 ± 0.4 | 6.0 ± 0.2 | 5.0 ± 0.4 |
Publisher’s Note: MDPI stays neutral with regard to jurisdictional claims in published maps and institutional affiliations. |
© 2022 by the authors. Licensee MDPI, Basel, Switzerland. This article is an open access article distributed under the terms and conditions of the Creative Commons Attribution (CC BY) license (https://creativecommons.org/licenses/by/4.0/).
Share and Cite
Yehuda, N.; Gheber, L.A.; Kushmaro, A.; Arad, S. Complexes of Cu–Polysaccharide of a Marine Red Microalga Produce Spikes with Antimicrobial Activity. Mar. Drugs 2022, 20, 787. https://doi.org/10.3390/md20120787
Yehuda N, Gheber LA, Kushmaro A, Arad S. Complexes of Cu–Polysaccharide of a Marine Red Microalga Produce Spikes with Antimicrobial Activity. Marine Drugs. 2022; 20(12):787. https://doi.org/10.3390/md20120787
Chicago/Turabian StyleYehuda, Nofar, Levi A. Gheber, Ariel Kushmaro, and Shoshana (Mails) Arad. 2022. "Complexes of Cu–Polysaccharide of a Marine Red Microalga Produce Spikes with Antimicrobial Activity" Marine Drugs 20, no. 12: 787. https://doi.org/10.3390/md20120787
APA StyleYehuda, N., Gheber, L. A., Kushmaro, A., & Arad, S. (2022). Complexes of Cu–Polysaccharide of a Marine Red Microalga Produce Spikes with Antimicrobial Activity. Marine Drugs, 20(12), 787. https://doi.org/10.3390/md20120787

